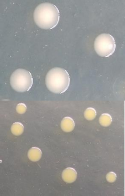
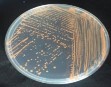
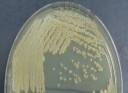
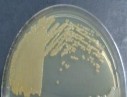
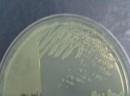
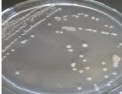
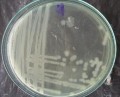
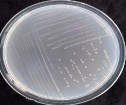
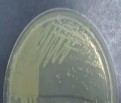
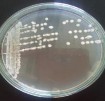
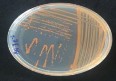

| Đại thể: Khuẩn lạc tròn, lồi nhầy, màu trắng đục, có tâm màu trắng đậm hơn ở giữa. Vi thể: Tế bào hình que, gram âm | ||
KL35 |
| Đại thể: Khuẩn lạc tròn, lồi, nhầy, màu vàng. Vi thể: tế bào hình cầu, gram âm. |
Có thể bạn quan tâm!
-
Nghiên cứu vi khuẩn chuyển hóa nitơ trong nền đáy vùng nuôi tôm hùm panulirus sp. phục vụ nuôi trồng thủy sản - 21 -
Khảo Sát Hàm Lượng Mật Rỉ Của P. Stutzeri Kl15 33 -
Phân Lập, Định Danh Vi Khuẩn Bacillus Và Khảo Sát Khả Năng Chuyển Hóa Ammonia Của Các Dòng Vi Khuẩn Bacillus -
Kết Quả Sinh Hóa Để Xác Định 2 Chủng Vi Khuẩn C9/1, T5/3 Thuộc Chi Bacillus Sp. ( Khóa Phân Loại Bergey). -
Đường Tuyến Tính Mật Số Vi Sinh Vật Với Od600Nm -
Một Số Hình Ảnh Của Lên Men Vi Sinh Vật Dạng Lỏng Và Bột.
Xem toàn bộ 247 trang tài liệu này.
1.3.4 Hình ảnh tra phần mềm phản ứng sinh hóa của nhóm vi khuẩn AOB/NOB
1.3.5 Kết quả trình tự của các dòng vi khuẩn chuyển hóa ammonia
Kết quả giải trình tự dòng KL2: TTGGAGAGTTTGATCCTGGCTCAGATTGAACGCTGGCGGCAGGCTTAACACATGCAAG TCGAGCGGGGGAAGGTAGCTTGCTACCGGACCTAGCGGCGGACGGGTGAGTAATGCT TAGGAATCTGCCTATTAGTGGGGGACAACATCTCGAAAGGGATGCTAATACCGCATAC GTCCTACGGGAGAAAGCAGGGGATCTTCGGACCTTGCGCTAATAGATGAGCCTAAGTC GGATTAGCTAGTTGGTGGGGTAAAGGCCTACCAAGGCGACGATCTGTAGCGGGTCTGA GAGGATGATCCGCCACACTGGGACTGAGACACGGCCCAGACTCCTACGGGAGGCAGC AGTGGGGAATATTGGACAATGGGGGGAACCCTGATCCAGCCATGCCGCGTGTGTGAA GAAGGCCTTATGGTTGTAAAGCACTTTAAGCGAGGAGGAGGCTACTCTAGTTAATACC TAGGGATAGTGGACGTTACTCGCAGAATAAGCACCGGCTAACTCTGTGCCACAGCCGC GGTAA.
Kết quả giải trình tự dòng KL10: AGAGTTTGATCCTGGCTCAGAACGAACGCTGGCGGCAGGCTTAACACATGCAAGTCGA GCGCCCCGCAAGGGGAGCGGCAGACGGGTGAGTAACGCGTGGGAACGTACCATTTGC TACGGAATAACTCAGGGAAACTTGTGCTAATACCGTATGAGCCCGAAAGGGGAAAGA TTTATCGGCAAATGATCGGCCCGCGTTGGATTAGCTAGTTGGTGGGGTAAAGGCCTAC CAAGGCGACGATCCATAGCTGGTCTGAGAGGATGATCAGCCACACTGGGACTGAGAC ACGGCCCAGACTCCTACGGGAGGCAGCAGTGGGGAATATTGGACAATGGGCGCAAGC CTGATCCAGCCATGCCGCGTGAGTGATGAAGGCCCTAGGGTTGTAAAGCTCTTTCACC GGTGAAGATAATGACGGTAACCGGAGAAGAAGCCCCGGCTAACTTCGTGCAGCAGCC GCGGTA.
Kết quả giải trình tự dòng KL11: TTGGAGAGTTTGATCCTGGCTCAGATTGAACGCTGGCGGCAGGCCTAACACATGCAAG TCGAGCGGATGAGTGGAGCTTGCTCCATGATTCAGCGGCGGACGGGTGAGTAATGCCT AGGAATCTGCCTGGTAGTGGGGGACAACGTTTCGAAAGGAACGCTAATACCGCATAC GTCCTACGGGAGAAAGTGGGGGATCTTCGGACCTCACGCTATCAGATGAGCCTAGGTC GGATTAGCTAGTTGGTGAGGTAAAGGCTCACCAAGGCGACGATCCGTAACTGGTCTGA GAGGATGATCAGTCACACTGGAACTGAGACACGGTCCAGACTCCTACGGAGGCAGCA
GTGGGGAATATTGGACAATGGGCGAAAGCCTGATCCAGCCATGCCGCGTGTGTGAAG AAGGTCTTCGGATTGTAAAGCACTTTAAGTTGGGAGGAAGGGCAGTAAGTTAATACCT TGCTGTTTTGACGTTACCAACAGAATAAGCACCGGCTAACTTCGTGCCAGCAGCCGCG GTAA
Kết quả giải trình tự dòng KL14: TTGGAGAGTTTGATCCTGGCTCAGATTGAACGCTGGCGGCAGGCCTAACACATGCAAG TCGAGCGGATGAGTGGAGCTTGCTCCATGATTCAGCGGCGGACGGGTGAGTAATGCCT AGGAATCTGCCTGGTAGTGGGGGACAACGTTTCGAAAGGAACGCTAATACCGCATAC GTCCTACGGGAGAAAGTGGGGGATCTTCGGACCTCACGCTATCAGATGAGCCTAGGTC GGATTAGCTAGTTGGTGAGGTAAAGGCTCACCAAGGCGACGATCCGTAACTGGTCTGA GAGGATGATCAGTCACACTGGAACTGAGACACGGTCCAGACTCCTACGGGAGGCAGC AGTGGGGAATATTGGACAATGGGCGAAAGCCTGATCCAGCCATGCCGCGTGTGTGAA GAAGGTCTTCGGATTGTAAAGCACTTTAAGTTGGGAGGAAGGGCAGTAAGTTAATACC TTGCTGTTTTGACGTTACCAACAGAATAAGCACCGGCTAACTTCGTGCCAGCAGCCCG CGGTA
Kết quả giải trình tự dòng KL15: CGCTAATACCGCATACGTCCTACGGGAGAAAGTGGGGGATCTTCGGACCTCACGCTAT CAGATGAGCCTAGGTCGGATTAGCTAGTTGGTGAGGTAAAGGCTCACCAAGGCGACG ATCCGTAACTGGTCTGAGAGGATGATCAGTCACACTGGAACTGAGACACGGTCCAGAC TCCTACGGGAGGCAGCAGTGGGGAATATTGGACAATGGGCGAAAGCCTGATCCAGCC ATGCCGCGTGTGTGAAGAAGGTCTTCGGATTGTAAAGCACTTTAAGTTGGGAGGAAGG GCAGTAAGTTAATACCTTGCTGTTTTGACGTTACCAACAGAATAAGCACCGGCTAACT TCGTGCCAGCAGCCGCGGTAATACGAAGGGTGCAAGCGTTAATCGGAATTACTGGG CGTAAAGCG.
Kết quả giải trình tự dòng KL21: TTGGAGAGTTTGATCCTGGCTCAGATTGAACGCTGGCGGCATGCTTTACACATGCAAG TCGAACGGCAGCGCGGGGCAACCTGGCGGCGAGTGGCGAACGGGTGAGTAATATATC GGAACGTACCCAAGAGTGGGGGATAACGTAGCGAAAGTTACGCTAATACCGCATACG ATCTATGGATGAAAGCAGGGGATCTTCGGACCTTGTGCTCCTGGAGCGGCCGATATCT GATTAGCTAGTTGGTGAGGTAAAGGCTCACCAAGGCGACGATCAGTAGCTGGTCTGAG AGGACGACCAGCCACACTGGAACTGAGACACGGTCCAGACTCCTACGGGAGGCAGCA GTGGGGAATTTTGGACAATGGGCGCAAGCCTGATCCAGCAATGCCGCGTGAGTGAAG AAGGCCTTCGGGTTGTAAAGCTCTTTGTCAGGGAAGAAACGGCTGTGGCTAATATCCA CGGCTAATGACGGTACCTGAAGAATAAGCACCGGCTAACTACGTGCCAGCAGCCGCG GTAA
Kết quả giải trình tự dòng KL26: GGCTCAGGATGAACGCTAGCGGCAGGCCTAATACATGCAAGTCGGACGGGATCCATC GGAGAGCTTGCTCGAAGATGGTGAGAGTGGCGCACGGGTGCGTAACGCGTGAGCAAC CTACCTCTATCAGGGGGATAGCCTCTCGAAAGAGAGATTAAACCGCATAACATCAACA GTTCGCATGTTCGGTTGATTAAATATTTATAGGATAGAGATGGGCTCGCGTGACATTA GCTAGTTGGTAGGGTAACGGCTTACCAAGGCGACGATGTCTAGGGGCTCTGAGAGGA GAATCCCCCACACTGGTACTGAGACACGGACCAGACTCCTACGGGAGGCAGCAGTAA GGAATATTGGTCAATGGGCGGAAGCCTGAACCAGCCATGCCGCGTGCAGGATGACTG CCCTATGGGTTGTAAACTGCTTTTGTCCAGGAATAAACCTAAATACGTGTATTTAGCTG AATGTACTGGAAGAATAAGGATCGGCTAACTC CGTGCCAGCAGCCGCGGT.
Kết quả giải trình tự dòng KL30: TTTGGAGAGTTTGATCCTGGCTCAGATTGAACGCTGGCGGCAGGCCTAACACATGCAA GTCGAGCGGTAACAGGGGAAGCTTGCTTCTCGCTGACGAGCGGCGGACGGGTGAGTA ATGTATGGGGATCTGCCCGATAGAGGGGGATAACTACTGGAAACGGTGGCTAATACC GCATAATCTCTTAGGAGCAAAGCAGGGGACCTTCGGGCCTTGCGCTGTCGGATGAACC CATATGGGATTAGCTAGTAGGTAAGGTAATGGCTTACCTAGGCGACGATCCCTAGCTG GTCTGAGAGGATGATCAGCCACACTGGGACTGAGACACGGCCCAGACTCCTACGGGA GGCAGCAGTGGGGAATATTGCACAATGGGCGCAAG CCTGATGCAGCCATGCCGCGTGTATGAAGAAGGCCCTAGGGTTGTAAAGTACTTTCAG TCGGGAGGAAGGCGTTGATGTTAATACCATCAACGATTGACGTTACCGACAGAAGAA GCACCGGCTAACTCCGTGCCAGCAGCCGCGGTAA
Kết quả giải trình tự dòng KL33: GATCCTGGCTCAGATTGAACGCTAGCGGGATGCTTTACACATGCAAGTCGAACGGCAG CGCGAGAGAGCTTGCTCTCTTGGCGGCGAGTGGCGGACGGGTGAGTAATATATCGGAA CGTGCCCAGTAGCGGGGGATAACTACTCGAAAGAGTGGCTATACCGCATACGCCCTAC GGGGGAAAGGGGGGGATCGCAAGACCTCTCACTATTGGAGCGGCCGATATCGGATTA GCTAGTTGGTGGGGTAAAGGCTCACCAAGGCAACGATCCGTAGCTGGTTTGAGAGGAC GACCAGCCACACTGGGACTGAGACACGGCCCAGACTCCTACGGGAGGCAGCAGTGGG GAATTTTGGACAATGGGGGAAACCCTGATCCAGCCATCCCGCGTGTATGATGAAGGCC TTCGGGTTGTAAAGTACTTTTGGCAGAGAAGAAAAGGTATCCCCTAATACGGGATACT GCTGACGGTATCTGCAGAATAAGCACCGGCTAACTACGTGCCAGCAGCCGCGGTA
Kết quả giải trình tự dòng KL35: ATCCTGGCTCAGGATGAACGCTGGCGGCGTGCTTAACACATGCAAGTCGAACGATGAA GCCCAGCTTGCTGGGTGGATTAGTGGCGAACGGGTGAGTAACACGTGAGTAACCTGCC CTTAACTCTGGGATAAGCCTGGGAAACTGGGTCTAATACCGGATAGGAGCGCCTACCG CATGGTGGGTGTTGGAAAGATTTATCGGTTTTGGATGGACTCGCGGCCTATCAGCTTGT TGGTGAGGTAATGGCTCACCAAGGCGACGACGGGTAGCCGGCCTGAGAGGGTGACCG GCCACACTGGGACTGAGACACGGCCCAGACTCCTACGGGAGGCAGCAGTGGGGAATA TTGCACAATGGGCGCAAGCCTGATGCGCGACGCCGCGTGAGGGATGACGGCCTTCGG GTTGTAAACCTCTTTCAGTAGGGAAGAAGCGAAAGTGACGGTACCTGCAGAAGAAGC ACCGGCTAACTACGTGCCAGCAGCCGC GGTAA.
1.3.6 Khảo sát chuyển hóa ammonia của 10 chủng vi khuẩn AOB Bảng 1.6 Hiệu suất chuyển hóa NH4+ của 10 dòng vi khuẩn AOB
Hiệu suất chuyển hóa NH4+ (%) | |||||||
1 ngày | 2 ngày | 3 ngày | 4 ngày | 5 ngày | 6 ngày | 7 ngày | |
KL2 | 18,2b ± 0,01 | 15,51g ± 0,02 | 26,8f ± 0,01 | 30,9j ± 0,06 | 67,28f ± 0,1 | 73,17d ± 0,07 | 78,38f ± 0,14 |
KL10 | 12,9d ± 0,11 | 17,51f ± 0,2 | 25,86g ± 0,05 | 36,53h ± 0,06 | 62,05h ± 0,18 | 69,43e ± 0,11 | 78,23fg ± 0,16 |
KL11 | 11,57e ± 0,08 | 20,84c ± 0,1 | 27,29f ± 0,06 | 34,45i ± 0,13 | 76,41d ± 0,21 | 64,86f ± 0,09 | 77,93g ± 0,1 |
KL14 | 15,62c ± 0,2 | 17,46f ± 0,2 | 35,07e ± 0,06 | 37,94g ± 0,27 | 57,25i ± 0,06 | 62,83g ± 0,03 | 79,93e ± 0,09 |
KL15 | 10,34f ± 0,05 | 19,13d ± 0,22 | 37,80d ± 0,08 | 39,07f ± 0,14 | 71,53e ± 0,23 | 75,63c ± 0,20 | 83,87c ± 0,01 |
KL21 | 11,21e ± 0,1 | 18,51e ± 0,1 | 25,73g ± 0,19 | 41,35e ± 0,07 | 55,23j ± 0,33 | 72,62d ± 0,22 | 80,91d ± 0,04 |
KL26 | 15,56c ± 0,17 | 35,12b ± 0,1 | 66,45c ± 0,21 | 90,31c ± 0,1 | 95,23c ± 0,16 | 95,19b ± 0,15 | 96,51b ± 0,12 |
KL30 | 30,51a ± 0,03 | 45,33a ± 0,22 | 75,56a ± 0,05 | 97,71a ± 0,21 | 97,83a ± 0,02 | 97,68a ± 0,18 | 97,65a ± 0,17 |
KL33 | 30,53a ± 0,15 | 45,28a ± 0,06 | 70,87b ± 0,06 | 96,20b ± 0,28 | 95,50b ± 0,2 | 97,10a ± 0,13 | 97,79a ± 0,10 |
KL35 | 15,24c ± 0,06 | 17,51f ± 0,18 | 35,08e ± 0,2 | 50,65d ± 0,17 | 64,62g ± 0,24 | 75,83c ± 0,08 | 80,35e ± 0,01 |
Trong cùng một cột, các giá trị có ký tự theo sau giống nhau không có sự khác biệt về mặt thống kê (P < 0,05).
1.4 Phân lập, định danh vi khuẩn NOB và khảo sát khả năng chuyển hóa nitrite của nhóm vi khuẩn
1.4.1 Thành phần môi trường
Môi trường nitrite – calcium – carbonate cho phân lập vi khuẩn chuyển hóa nitrite dựa trên phương pháp của Ehrlich, 1975
0,005g | |
K2HPO4 | 1g |
0,1g | |
NaCl | 0,3g |
CaCO3 CaCl2 | 1g 0,3g |
pH = 8 |
Môi trường nuôi tăng sinh cho vi khuẩn chuyển hóa nitrite dựa trên phương pháp (Aleem và Alexande, 1960).
0,3g | |
KH2PO4 | 0,175g |
MgSO4.7H2O | 0,175g |
NaCl | 0,1g |
KHCO3 FeSO4.7H2O Agar | 1,5g 0,35µg 15g |
1.4.2 Phân lập và định danh nhóm vi khuẩn chuyển hóa nitrite

Hình 1.9 Sự hiện diện của vi khuẩn NOB trong mẫu bùn
Ghi chú: trắng, hồng (+), đỏ (-)
Bảng 1.7 Mật độ vi khuẩn của nhóm NOB trong mẫu bùn
Ký hiệu mẫu | Kếtquả (MPN/g) | STT | Ký hiệu mẫu | Kếtquả (MPN/g) | |
1 | CKT | 4,6x104 | 12 | TKT | 2,8x103 |
2 | C1 | 4,6x102 | 13 | T1 | 7,5x103 |
3 | C2 | 1,1x105 | 14 | T2 | 9,3x103 |
4 | C3 | 4,3x103 | 15 | T3 | 2,8x103 |
5 | C4 | 2,4x104 | 16 | T4 | 4,3x103 |
6 | C5 | 1,5 x 102 | 17 | T5 | 4,6x104 |
7 | C6 | 4,3 x 102 | 18 | T6 | 0,92 x 102 |
8 | C7 | 2,4 x 102 | 19 | T7 | 1,1 x 104 |
9 | C8 | 2,0 x 103 | 20 | T8 | 2,1 x 102 |
10 | C9 | 0,92 x103 | 21 | T9 | 2,0 x 103 |
11 | C10 | 2,0 x 103 | 22 | T10 | 2,2 x 102 |
Bảng 1.8 Khả năng chuyển hóa NO2 - của các chủng vi khuẩn NOB
Chuyển hóa NO2- | Dòng | Chuyển hóa NO2- | |
CKC | + + + + | C9/4 | + + |
C1/2 | + + + | C10 | + + + + |
C1/3 | + | TKT | + + + + |
C2/1 | + + + + | T1 | + + + + |
+ + + + | T2/1 | + | |
C2/3 | + + | T2/2 | + + + + |
C2/4 | + | T3/1 | + + + + |
C3/1 | + + + + | T3/2 | + + |
C4/2 | + + + + | T3/3 | + + + |
C4/3 | + + | T4/1 | + + + + |
C5/1 | + + + | T4/2 | + |
C5/3 | + + + | T5/2 | + + |
C5/5 | + | T5/3 | + + + + |
C6/1 | + | T6 | + |
C6/2 | + + + | T7/1 | + |
C7 | + + | T7/3 | + + + + |
C8/1 | + + + + | T8/1 | + + |
C8/4 | + | T8/2 | + + |
C9/1 | + + + + | T9 | + + + + |
C9/3 | + + | T10 | + + + + |
Ghi chú: (+) rất yếu, (+ +) yếu, (+ + +) vừa, (+ + + +) mạnh
Hình 1.10 Một số khuẩn lạc NOB phân lập tại Vịnh Xuân Đài
Hình 1.11 Định tính khả năng chuyển hóa nitrite của chủng vi khuẩn NOB.
Bảng 1.9 Phản ứng sinh hóa của các chủng vi khuẩn NOB
Ký hiệu chủng vi khuẩn | Khuẩn lạc | Nhuộm Gram | Mô tả | |
1 | CKT |
|
| Khuẩn lạc tròn, lồi, nhầy, màu vàng đục. Tế bào hình que, gram âm, không đi động, không sinh bào tử, catalase (+), phát triển yếu trên môi trường NaCl 3% |
2 | C2/1 |
|
| Khuẩn lạc tròn, lồi, nhầy, màu vàng đục Tế bào hình que, gram âm, không đi động, không sinh bào tử, catalase (+), phát triển yếu trên môi trường NaCl 3% |
3 | C2/2 | Khuẩn lạc tròn, lồi, nhầy, màu trắng đục. Tế bào hình que, gram âm, không di động, không sinh bào tử, catalase (+), phát triển trên môi trường NaCl 3% | ||
4 | C3/1 | Khuẩn lạc tròn, lồi, nhầy, màu trắng đục Tế bào hình que, gram âm, không di động, không sinh bào tử, catalase (+), phát triển trên môi trường NaCl 3 và 4,5%, phát triển mạnh ở nhiệt độ 42oC | ||
5 | C4/2 |
|
| Khuẩn lạc tròn, lồi, nhầy, màu trắng đục Tế bào hình que, gram âm, không di động, không sinh bào tử, catalase (+), phát triển trên môi trường NaCl 3% |
6 | C8/1 |
|
| Khuẩn lạc tròn, lồi, màu trắng đục. Tế bào hình que, gram dương,di động, không sinh bào tử, catalase (+), phát triển trên môi trường NaCl 3% |
7 | C9/1 |
|
| Khuẩn lạc lồi, nhầy, màu trắng đục. Tế bào hình que, gram dương, sinh bào tử, di động, catalase (+), phát triển trên môi trường NaCl 3% |
8 | C10 |
|
| Khuẩn lạc màu trắng trong. Tế bào hình que, gram dương, sinh bào tử, di động, catalase (+), phát triển trên môi trường NaCl 3%. |
TKT |
|
| Khuẩn lạc tròn, lồi, nhầy, màu trắng đục Tế bào hình que, gram âm, không sinh bào tử, không di động, catalase (+), phát triển trên môi trường NaCl 3% | |
10 | T1 |
| Khuẩn lạc tròn, lồi, nhầy, màu trắng đục Tế bào hình que, gram âm, không di động, không sinh bào tử, catalase (+), phát triển trên môi trường NaCl 3 và 4,5%, phát triển mạnh ở nhiệt độ 42oC | |
11 | T2/2 |
| Khuẩn lạc tròn, lồi, nhầy, màu trắng đục Tế bào hình que, gram âm, không di động, không sinh bào tử, catalase (+), phát triển trên môi trường NaCl 3% | |
12 | T3/1 |
| Khuẩn lạc tròn, lồi, nhầy, màu trắng đục Tế bào hình que, gram âm, di động, không sinh bào tử, catalase (+), phát triển trên môi trường NaCl 3% | |
13 | T4/1 |
|
| Khuẩn lạc tròn, lồi, nhầy, màu trắng trong Tế bào hình que, gram âm, không di động, không sinh bào tử, catalase (+), phát triển trên môi trường NaCl 3% |
14 | T5/3 |
|
| Khuẩn lạc tròn, lồi, nhầy, màu trắng đục. Tế bào hình que, gram dương, sinh bào tử, di động, sinh bào tử, catalase (+), phát triển trên môi trường NaCl 3% |
15 | T7/3 | Khuẩn lạc màu đỏ cam, Tế bào hình que, gram dương, sinh bào tử, không di động, sinh bào tử, catalase (+), oxidase (-), phát triển trên môi trường NaCl 3% | ||
16 | T9 |
|
| Khuẩn lạc màu đỏ cam, Tế bào hình que, gram dương, sinh bào tử, không di động, sinh bào tử, catalase (+), oxidase (-), phát triển trên môi trường NaCl 3% |

1.4.3 Kết quả giải trình tự
Kết quả giải trình tự dòng TKT AGTGAACGCTGGCGGTAGGCCTAACACATGCAAGTCGAACGGCAGCACAGGAGAGCT TGCTCTCTGGGTGGCGAGTGGCGGACGGGTGAGGAATACATCGGAATCTACTCTGTCG TGGGGGATAACGTAGGGAAACTTACGCTAATACCGCATACGACCTACGGGTGAAAGC
AGGGGACCTTCGGGCCTTGCGCGATTGAATGAGCCGATGTCGGATTAGCTAGTTGGCG GGGTAAAGGCCCACCAAGGCGACGATCCGTAGCTGGTCTGAGAGGATGATCAGCCAC ACTGGAACTGAGACACGGTCCAGACTCCTACGGGAGGCAGCAGTGGGGAATATTGGA CAATGGGCGCAAGCCTGATCCAGCCATACCGCGTGGGTGAAGAAGGCCTTCGGGTTGT AAAGCCCTTTTGTTGGGAAAGAAATCCAGCTGGCTAATACCTGGTTGGGATGACGGTA CCCAAAGAATAAGCACCGGCTAACTTCGT GC
Kết quả giải trình tự dòng CKT TCAGGATGAACGCTAGCGGGAGGCCTAACACATGCAAGCCGAGCGGTAGAGATCTTT CGGGATCTTGAGAGCGGCGTACGGGTGCGGAACACGTGTGCAACCTGCCTTTATCAGG GGGATAGCCTTTCGAAAGGAAGATTAATACCCCATAATATATTGAGTGGCATCACTTA ATATTGAAAACTCCGGTGGATAGAGATGGGCACGCGCAAGATTAGATAGTTGGTGAG GTAACGGCTCACCAAGTCTGCGATCTTTAGGGGGCCTGAGAGGGTGATCCCCCACACT GGTACTGAGACACGGACCAGACTCCTACGGGAGGCAGCAGTGAGGAATATTGGACAA TGGGTGCGAGCCTGATCCAGCCATCCCGCGTGAAGGACGACGGCCCTATGGGTTGTAA ACTTCTTTTGTATAGGGATAAACCTACTCTCGTGAGAGTAGCTGAAGGTACTATACGA ATAAGCACCGGCTAACTCC
Kết quả giải trình tự dòng C2/2 AGTGAACGCTGGCGGTAGGCCTAACACATGCAAGTCGAACGGCAGCACAGGAGAGCT TGCTCTCTGGGTGGCGAGTGGCGGACGGGTGAGGAATACATCGGAATCTACTCTGTCG TGGGGGATAACGTAGGGAAACTTACGCTAATACCGCATACGACCTACGGGTGAAAGC AGGGGACCTTCGGGCCTTGCGCGATTGAATGAGCCGATGTCGGATTAGCTAGTTGGCG GGGTAAAGGCCCACCAAGGCGACGATCCGTAGCTGGTCTGAGAGGATGATCAGCCAC ACTGGAACTGAGACACGGTCCAGACTCCTACGGGAGGCAGCAGTGGGGAATATTGGA CAATGGGCGCAAGCCTGATCCAGCCATACCGCGTGGGTGAAGAAGGCCTTCGGGTTGT AAAGCCCTTTTGTTGGGAAAGAAATCCAGCTGGCTAATACCCGGTTGGGATGACGGTA CCCAAAGAATAAGCACCGGC
Kết quả giải trình tự dòng C4/2 TGATCCTGGCTCAGAGTGAACGCTGGCGGTAGGCCTAACACATGCAAGTCGAACGGCA GCACAGGAGAGCTTGCTCTCTGGGTGGCGAGTGGCGGACGGGTGAGGAATACATCGG AATCTACTCTGTCGTGGGGGATAACGTAGGGAAACTTACGCTAATACCGCATACGACC TACGGGTGAAAGCAGGGGACCTTCGGGCCTTGCGCGATTGAATGAGCCGATGTCGGAT TAGCTAGTTGGCGGGGTAAAGGCCCACCAAGGCGACGATCCGTAGCTGGTCTGAGAG GATGATCAGCCACACTGGAACTGAGACACGGTCCAGACTCCTACGGGAGGCAGCAGT GGGGAATATTGGACAATGGGCGCAAGCCTGATCCAGCCATACCGCGTGGGTGAAGAA GGCCTTCGGGTTGTAAAGCCCTTTTGTTGGG AAAGAAATCCA
Kết quả giải trình tự dòng C3/1 TGATCCTGGCTCAGAGTGAACGCTGGCGGTAGGCCTAACACATGCAAGTCGAACGGCA GCACAGGAGAGCTTGCTCTCTGGGTGGCGAGTGGCGGACGGGTGAGGAATACATCGG AATCTACTCTGTCGTGGGGGATAACGTAGGGAAACTTACGCTAATACCGCATACGACC TACGGGTGAAAGCAGGGGACCTTCGGGCCTTGCGCGATTGAATGAGCCGATGTCGGAT TAGCTAGTTGGCGGGGTAAAGGCCCACCAAGGCGACGATCCGTAGCTGGTCTGAGAG GATGATCAGCCACACTGGAACTGAGACACGGTCCAGACTCCTACGGGAGGCAGCAGT GGGGAATATTGGACAATGGGCGCAAGCCTGATCCAGCCATACCGCGTGGGTGAAGAA GGCCTTCGGGTTGTAAAGCCCTTTTGTTGGGAAAGAAATCCA
Kết quả giải trình tự dòng T3/1 TGGCTCAGATTGAACGCTGGCGGCATGCCTTACACATGCAAGTCGAACGGTAACAGGT CTTCGGACGCTGACGAGTGGCGAACGGGTGAGTAATACATCGGAACGTGCCCAGTCGT GGGGGATAACTACTCGAAAGAGTAGCTAATACCGCATACGTCTGAGGATGAAAGCGG GGGACCTTCGGGCCTCGCGCGATTGGAGCGGCCGATGGCAGATTAGGTAGTTGGTGGG ATAAAAGCTTACCAAGCCGACGATCTGTAGCTGGTCTGAGAGGACGACCAGCCACACT GGGACTGAGACACGGCCCAGACTCCTACGGGAGGCAGCAGTGGGGAATTTTGGACAA